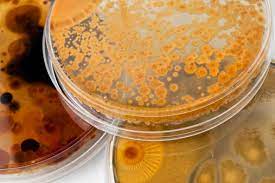

The global Technical Enzymes Market report offers a comprehensive assessment of the market for the forecast years. The report contains several segments and an analysis of the market trends and growth factors that are playing a vitalrole in the market. These factors encompass the drivers, restraints, and opportunities. This global industry offers an outlook on the strategic development of the market in terms of revenue profits over the forecast period 2021-2026.
The key market players for the global Technical Enzymes market are listed below:
- Novozymes
- SunHY
- Associated British Foods
- DowDuPont
- Advanced Enzyme Technologies
- BASF
- VTR Bio-Tech
- DSM
- MAPS Enzyme
- Others
Click here to get a FREE Sample Copy of the Technical Enzymes Market Research Report @ https://www.decisiondatabases.com/contact/download-sample-29669
The Global Technical Enzymes Market Report is equipped with market data from 2016 to 2026. The report gives a market overview covering key drivers and risk factors. The report is bifurcated by top global manufactures mentioning sales, revenue, and prices as applicable. It also evaluates the competitive scenario of the leading players. The report expands to cover regional market data along with type and application. The report forecasts sales and revenue from 2021 to 2026. The detailed sales channel is also covered in the study.
COVID-19 Impact Analysis on Technical Enzymes Market
The global pandemic COVID-19 has affected the Technical Enzymes market directly or indirectly. This study covers a separate section giving an explicitly clear understanding of the aftereffects of this pandemic. The detailed study highlights the probable outcomes of this global crisis on the Technical Enzymes industry. The impact study on production, supply-demand, and sales provides a holistic approach to the future.
Do You Have Any Query Or Report Customization? Ask Our Market Expert @ https://www.decisiondatabases.com/contact/ask-questions-29669
Why Purchase this Report?
- A robust research methodology has been followed to collect data for the report. Data, thus collected passes through multiple quality checks to ensure the best quality is served.
- The report gives a holistic view of the competitive scenario of the Technical Enzymes market
- The latest product launches along with technological changes and development are covered in the report.
- The data analysis in the report helps in understanding the anticipated Technical Enzymes market dynamics from 2021 to 2026.
- DecisionDatabases has a vast repository of data, therefore, we can accommodate customized requirements also.
- The graphs, tables and pie charts, and info-graphics covered in the report will help in a better understanding of the report.
- The market drivers, restraints, upcoming opportunities, and anticipated restraints cited in the report will assist in making an informed decision.
To better understand the market scenario, the Technical Enzymes market is segmented as below:
By Types:
- Amylases
- Cellulases
- Proteases
- Lipases
- Other
By Applications:
- Detergents
- Bioethanol
- Paper & Pulp
- Textile & Leather
- Other
By Regions:
- North America (U.S., Canada, Mexico)
- Europe (U.K., France, Germany, Spain, Italy, Central & Eastern Europe, CIS)
- Asia Pacific (China, Japan, South Korea, ASEAN, India, Rest of Asia Pacific)
- Latin America (Brazil, Rest of L.A.)
- The Middle East and Africa (Turkey, GCC, Rest of Middle East)
The content of the study subjects includes a total of 14 chapters:
Chapter 1: To describe Technical Enzymes product scope, market overview, market opportunities, market driving force, and market risks.
Chapter 2: To profile the top manufacturers of Technical Enzymes, with price, sales, revenue, and global market share of Technical Enzymes in 2018 and 2019.
Chapter 3: The Technical Enzymes competitive situation, sales, revenue, and global market share of top manufacturers are analyzed emphatically by landscape contrast.
Chapter 4: The Technical Enzymes breakdown data are shown at the regional level, to show the sales, revenue, and growth by region, from 2015 to 2020.
Chapter 5 and 6: To segment the sales by type and application, with sales market share and growth rate by type, application, from 2015 to 2020.
Chapter 7, 8, 9, 10 & 11: To break the sales data at the country level, with sales, revenue, and market share for key countries in the world, from 2016 to 2021 and Technical Enzymes market forecast, by regions, type, and application, with sales and revenue, from 2021 to 2026.
Chapter 12, 13 & 14: To describe Technical Enzymes sales channel, distributors, customers, research findings and conclusion, appendix, and data source.
Directly Purchase the Complete Global Technical Enzymes Market Research Report @ https://www.decisiondatabases.com/contact/buy-now-29669
About Us:
DecisionDatabases.com is a global business research report provider, enriching decision-makers, and strategists with qualitative statistics. DecisionDatabases.com is proficient in providing syndicated research reports, customized research reports, company profiles, and industry databases across multiple domains. Our expert research analysts have been trained to map client’s research requirements to the correct research resource leading to a distinctive edge over its competitors. We provide intellectual, precise, and meaningful data at a lightning speed.
For more details:
DecisionDatabases.com
E-Mail: sales@decisiondatabases.com
Phone: +91 90 28 057900
Web: https://www.decisiondatabases.com/
Reference Source: